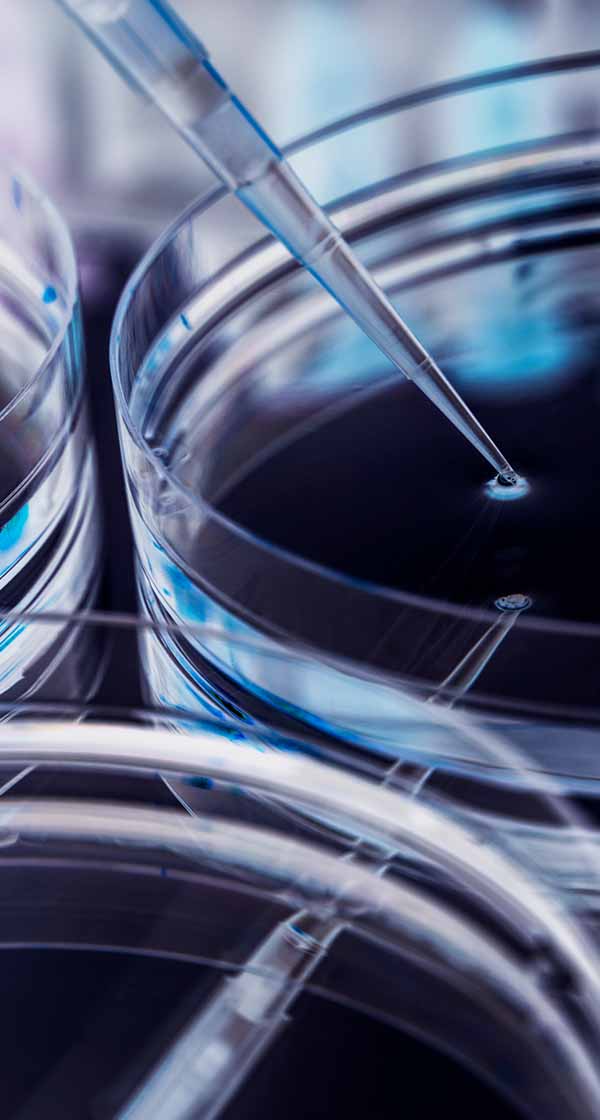

쿠팡로지스틱스서비스 쿠팡CLS 물류관리자 채용
쿠팡로지스틱스서비스 쿠팡CLS 물류관리자 채용
 각 지역에 있는 물류센터에서
각 지역에 있는 물류센터에서 ㈜파마리서치 직무특화 채용연계형(MR)
㈜파마리서치 직무특화 채용연계형(MR)
 2001년 설립 (25년차)
2001년 설립 (25년차) (주)세경하이테크 각 포지션 경력 인재 모집 각 포지션 경력 인재 모집 코스닥 상장사 ~06.26(목)
(주)세경하이테크 각 포지션 경력 인재 모집 각 포지션 경력 인재 모집 코스닥 상장사 ~06.26(목) 
 2006년 설립 (20년차)
2006년 설립 (20년차) 연세대학교 정규직원(6급/8급) 채용 정규직원(6급/8급) 채용 2호선 역세권 기업 D-5
연세대학교 정규직원(6급/8급) 채용 정규직원(6급/8급) 채용 2호선 역세권 기업 D-5 

 사단법인 벤처기업협회 2025년 우수벤처기업
사단법인 벤처기업협회 2025년 우수벤처기업 
 혁신적인 기술력으로
혁신적인 기술력으로 HD현대오일뱅크 [HD현대케미칼]
HD현대오일뱅크 [HD현대케미칼]![[HD현대케미칼]각 부문 경력 채용](https://www.saraminbanner.co.kr/banner_logo/company/logo_banner/2025/06/sxbq7x46_2jiz-2so27k_.jpg)
![[HD현대케미칼]각 부문 경력 채용](https://www.saraminbanner.co.kr/banner_logo/company/logo_banner/2025/06/sxbq7z67_z270-2so27k_.jpg)
 삼성전자 삼성전자 협력사 채용관
삼성전자 삼성전자 협력사 채용관
 삼성전자 우수 협력사에서
삼성전자 우수 협력사에서 웹케시㈜ 인사/급여 담당자
웹케시㈜ 인사/급여 담당자
 "B2B핀테크&SaaS전문기업"
"B2B핀테크&SaaS전문기업" 한국투자증권 FY2025 AI전문인력
한국투자증권 FY2025 AI전문인력
 1974년 설립 (52년차)
1974년 설립 (52년차) ㈜알토 2025 하반기
㈜알토 2025 하반기
 1976년 설립 (50년차)
1976년 설립 (50년차) 한국오츠카제약(주) 병원영업 채용연계형
한국오츠카제약(주) 병원영업 채용연계형
 "한국 의료에 공헌하는 회사"를
"한국 의료에 공헌하는 회사"를  ㈜이마트 점포 신선직무
㈜이마트 점포 신선직무 
 2011년 설립 (15년차)
2011년 설립 (15년차) 차병원·차바이오그룹 세포&유전자치료제 줄기세포
차병원·차바이오그룹 세포&유전자치료제 줄기세포
 1960년 설립 (66년차)
1960년 설립 (66년차) 미우미우 백화점 · 면세점
미우미우 백화점 · 면세점
 1995년 설립 (31년차)
1995년 설립 (31년차) (주)포스코인터내셔널 2025년
(주)포스코인터내셔널 2025년
 "그린에너지와 글로벌 비즈니스로
"그린에너지와 글로벌 비즈니스로 쿠팡로지스틱스서비스 쿠팡CLS 현장 운영&사무보조
쿠팡로지스틱스서비스 쿠팡CLS 현장 운영&사무보조
 경력무관, 초보도 가능한
경력무관, 초보도 가능한 주식회사 에이치시티 2025년 신입/경력 공개채용 2025년 신입/경력 공개채용 코스닥 상장사 D-4
주식회사 에이치시티 2025년 신입/경력 공개채용 2025년 신입/경력 공개채용 코스닥 상장사 D-4 
 국내를 넘어 세계를 향해
국내를 넘어 세계를 향해  ㈜세종분석연구원 각 부문별
㈜세종분석연구원 각 부문별

 K Car 안전관리자
K Car 안전관리자 
 K Car에 많은 관심 부탁드립니다.
K Car에 많은 관심 부탁드립니다.  네이버 네이버 검색광고 파트너사
네이버 네이버 검색광고 파트너사 
 네이버 검색광고 파트너사는
네이버 검색광고 파트너사는 주택도시보증공사 2025년도 정규직 채용
주택도시보증공사 2025년도 정규직 채용
 1999년 설립 (27년차)
1999년 설립 (27년차) NAVER Cloud 25년 경력 채용 25년 경력 채용 매출액 1조 이상 D-5
NAVER Cloud 25년 경력 채용 25년 경력 채용 매출액 1조 이상 D-5 
 대한민국 최고의 IT 기업을 넘어
대한민국 최고의 IT 기업을 넘어 클리오 상반기신입(인턴)
클리오 상반기신입(인턴)
 1997년 설립 (29년차)
1997년 설립 (29년차) 사단법인 대덕이노폴리스벤처협회 비수도권 벤처기업 온라인
사단법인 대덕이노폴리스벤처협회 비수도권 벤처기업 온라인
 협회에서는 중소벤처기업부와 함께
협회에서는 중소벤처기업부와 함께 kt ds 2025년 부문별
kt ds 2025년 부문별
 2008년 설립 (18년차)
2008년 설립 (18년차) 고용노동부 인재채움(대체인력)전용관
고용노동부 인재채움(대체인력)전용관
 근로자는 당당한 출산과 육아휴직,
근로자는 당당한 출산과 육아휴직, ㈜오아시스 의왕물류센터(오전/오후/야간)
㈜오아시스 의왕물류센터(오전/오후/야간)
 좋은 품질의 식품을 유통하고
좋은 품질의 식품을 유통하고 HD현대오일뱅크 중앙기술연구원
HD현대오일뱅크 중앙기술연구원

 ㈜신세계푸드 이천공장 공무관리(보일러)
㈜신세계푸드 이천공장 공무관리(보일러)
 식생활 문화를 선도하는
식생활 문화를 선도하는 키엔스코리아㈜ 2025년 신입사원 채용
키엔스코리아㈜ 2025년 신입사원 채용 
 2004년 설립 (22년차)
2004년 설립 (22년차) 한국도로공사서비스(주) 2025년 하반기 기간제근로자
한국도로공사서비스(주) 2025년 하반기 기간제근로자
 2019년 설립 (7년차)
2019년 설립 (7년차) (주)셀트리온제약 신입/경력 수시채용
(주)셀트리온제약 신입/경력 수시채용
2000년 설립 (26년차)
2000년 설립 (26년차) ㈜쎄트렉아이 경력직 채용 경력직 채용 코스닥 상장사 D-4
㈜쎄트렉아이 경력직 채용 경력직 채용 코스닥 상장사 D-4 
 1999년 설립 (27년차)
1999년 설립 (27년차) ㈜오아시스 성남물류센터(오전/오후/야간)
㈜오아시스 성남물류센터(오전/오후/야간)
 좋은 품질의 식품을 유통하고
좋은 품질의 식품을 유통하고 두산에너빌리티(주) 2025 채용연계형 인턴 대규모 채용 2025 채용연계형 인턴 대규모 채용 대기업 D-5
두산에너빌리티(주) 2025 채용연계형 인턴 대규모 채용 2025 채용연계형 인턴 대규모 채용 대기업 D-5 
 1962년 설립 (64년차)
1962년 설립 (64년차) 현대종합금속㈜ 신입 사원 모집 신입 사원 모집 기업 조회 TOP100 ~06.22(일)
현대종합금속㈜ 신입 사원 모집 신입 사원 모집 기업 조회 TOP100 ~06.22(일) 
 1975년 설립 (51년차)
1975년 설립 (51년차) 나이스평가정보㈜ 상반기 각 부문
나이스평가정보㈜ 상반기 각 부문

 ㈜시몬스 각 부문별
㈜시몬스 각 부문별

 ㈜선진 2025년 2분기
㈜선진 2025년 2분기

 (주)SPC삼립 각 부문별
(주)SPC삼립 각 부문별

 토스뱅크 여신 도메인
토스뱅크 여신 도메인 

 (주)연합인포맥스 경력기자 모집
(주)연합인포맥스 경력기자 모집

 ㈜이엠넷 크리에이티브본부
㈜이엠넷 크리에이티브본부 

 LG에너지솔루션 LG에너지솔루션 협력사 채용관
LG에너지솔루션 LG에너지솔루션 협력사 채용관 배터리 에너지
배터리 에너지  CJ대한통운㈜ 2025년
CJ대한통운㈜ 2025년 인천전체신입고졸↑ 코스피 상장사 ~06.16(월)
인천전체신입고졸↑ 코스피 상장사 ~06.16(월)  금천구청 금천구 온라인 채용관
금천구청 금천구 온라인 채용관 온라인 일자리 박람회
온라인 일자리 박람회  토스뱅크 여신 도메인
토스뱅크 여신 도메인 서울 강남구경력무관학력무관 관심기업 TOP100 ~06.15(일)
서울 강남구경력무관학력무관 관심기업 TOP100 ~06.15(일)  바이오헬스기업
바이오헬스기업  신평택발전(주) LNG분야
신평택발전(주) LNG분야 경기 평택시4 ~ 10년대학교(4년)↑ 한국전력공사 계열사 D-5
경기 평택시4 ~ 10년대학교(4년)↑ 한국전력공사 계열사 D-5  중소기업중앙회 이달의 우수 중소기업 일자리 전용 채용관
중소기업중앙회 이달의 우수 중소기업 일자리 전용 채용관 우수중소기업 일자리
우수중소기업 일자리  코웨이 코웨이 파트너사 온라인 채용관
코웨이 코웨이 파트너사 온라인 채용관 코웨이 파트너사
코웨이 파트너사  (주)SPG수소 경영기획/관리, 영업, SCM
(주)SPG수소 경영기획/관리, 영업, SCM 경기 성남시 분당구경력대학교(4년)↑ 지원 TOP100 (영업·판매·무역) D-4
경기 성남시 분당구경력대학교(4년)↑ 지원 TOP100 (영업·판매·무역) D-4  케이엔솔(주) 2025년 상반기 경력직 채용
케이엔솔(주) 2025년 상반기 경력직 채용 서울 강남구경력대학(2,3년)↑ 코스닥 상장사 D-7
서울 강남구경력대학(2,3년)↑ 코스닥 상장사 D-7  정보통신기획평가원 AI·디지털인재얼라이언스 채용관
정보통신기획평가원 AI·디지털인재얼라이언스 채용관 AI디지털기업
AI디지털기업  SK지오센트릭 SK지오센트릭 협력회사 채용관
SK지오센트릭 SK지오센트릭 협력회사 채용관 SK지오센트릭 협력사
SK지오센트릭 협력사 ![[NICE그룹] KIS정보통신](https://www2.saraminbanner.co.kr/banner_logo/company/logo_banner/2024/09/sk3lxv_k7rc-2so33z_platinum69979KISlogo.png) [NICE그룹] KIS정보통신 정규직(신입) 및 계약직
[NICE그룹] KIS정보통신 정규직(신입) 및 계약직 서울 구로구신입 · 경력대학교(4년)↑ 매출액 1000억 이상 D-4
서울 구로구신입 · 경력대학교(4년)↑ 매출액 1000억 이상 D-4  한국핀테크지원센터 핀테크기업 온라인 채용관
한국핀테크지원센터 핀테크기업 온라인 채용관 핀테크 금융 IT
핀테크 금융 IT  쿠팡풀필먼트서비스 자동화 설비보전 전문가
쿠팡풀필먼트서비스 자동화 설비보전 전문가 전국신입 · 경력학력무관 관심기업 TOP100 ~06.30(월)
전국신입 · 경력학력무관 관심기업 TOP100 ~06.30(월)  커넥트현대 청주 커넥트현대청주 온라인 채용박람회
커넥트현대 청주 커넥트현대청주 온라인 채용박람회 커넥트현대청주
커넥트현대청주  (사)벤처기업협회 2025년 청년일자리 강소기업
(사)벤처기업협회 2025년 청년일자리 강소기업 청년일자리 강소기업
청년일자리 강소기업  ㈜올가홀푸드 [풀무원] ORGA
㈜올가홀푸드 [풀무원] ORGA![[풀무원] ORGA본사_재무관리팀,수도권_매장관리](https://www2.saraminbanner.co.kr/banner_logo/company/logo_banner/2025/06/sx7yzj44_tfb3-2so28p_ac.png) 서울 송파구신입 · 경력대학(2,3년)↑ 매출액 500억 이상 D-6
서울 송파구신입 · 경력대학(2,3년)↑ 매출액 500억 이상 D-6  현대자동차그룹 현대자동차그룹 협력사 수시채용관
현대자동차그룹 현대자동차그룹 협력사 수시채용관 자동차 채용박람회
자동차 채용박람회  서울특별시관광협회 서울 관광산업 채용관
서울특별시관광협회 서울 관광산업 채용관 서울시 관광기업
서울시 관광기업  여수광양항만공사 YG Job바다 온라인 채용관
여수광양항만공사 YG Job바다 온라인 채용관 여수 광양 지역인재
여수 광양 지역인재  유니셈㈜ 반도체 장비 엔지니어
유니셈㈜ 반도체 장비 엔지니어 경기 평택시신입 · 경력고졸↑ 기업 조회 TOP100 ~06.12(목)
경기 평택시신입 · 경력고졸↑ 기업 조회 TOP100 ~06.12(목)  쥬비스다이어트(주) 신입사원(인턴)
쥬비스다이어트(주) 신입사원(인턴) 서울 강남구신입학력무관 매출액 500억 이상 D-5
서울 강남구신입학력무관 매출액 500억 이상 D-5  인솔㈜ 2025년
인솔㈜ 2025년 경기 하남시신입 · 경력대학교(4년)↑ 매출액 100억 이상 D-7
경기 하남시신입 · 경력대학교(4년)↑ 매출액 100억 이상 D-7  점핏 IT 개발자만을 위한 전문 채용관
점핏 IT 개발자만을 위한 전문 채용관 IT개발자 채용플랫폼
IT개발자 채용플랫폼  SK텔레콤 SK텔레콤 Biz Partner 채용관
SK텔레콤 SK텔레콤 Biz Partner 채용관 SKT Biz파트너 ICT
SKT Biz파트너 ICT  쿠팡 주식회사 일본 사업 담당자 대규모
쿠팡 주식회사 일본 사업 담당자 대규모 쿠팡 주식회사 이츠 영업사원 대규모 채용 서울 강남구경력무관고졸↑ 조회 TOP100 (영업·판매·무역) D-7
쿠팡 주식회사 이츠 영업사원 대규모 채용 서울 강남구경력무관고졸↑ 조회 TOP100 (영업·판매·무역) D-7  한국상하수도협회 환경부 제34기 물산업
한국상하수도협회 환경부 제34기 물산업  ㈜우리환경기술 2025 신입 경력
㈜우리환경기술 2025 신입 경력  쿠팡풀필먼트서비스 물류,엔지니어,경영
쿠팡풀필먼트서비스 물류,엔지니어,경영  ㈜케이씨씨글라스 6월 신입/경력사원
㈜케이씨씨글라스 6월 신입/경력사원 